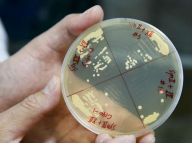
“再造生命”：迈进一大步

记录
-
 5页2017-03-14
边防:他们的身后是祖国查看:573次
5页2017-03-14
边防:他们的身后是祖国查看:573次
-
11页2017-03-13
“再造生命”:迈进一大步查看:638次
11页2017-03-13
“再造生命”:迈进一大步查看:638次
-
 5页2017-03-10
华尔街铜牛前现“无畏女孩”查看:1263次
5页2017-03-10
华尔街铜牛前现“无畏女孩”查看:1263次
-
 10页2017-03-09
榜单:年度最具幸福感城市查看:789次
10页2017-03-09
榜单:年度最具幸福感城市查看:789次
-
 4页2017-03-08
韩国民众抗议“萨德”入韩查看:793次
4页2017-03-08
韩国民众抗议“萨德”入韩查看:793次
-
 7页2017-03-08
伊拉克战事掠影:逃离战区查看:478次
7页2017-03-08
伊拉克战事掠影:逃离战区查看:478次
-
 17页2017-03-08
【两会】三八妇女节特刊查看:2604次
17页2017-03-08
【两会】三八妇女节特刊查看:2604次
-
 3页2017-03-07
特检组认定朴槿惠多项嫌疑查看:353次
3页2017-03-07
特检组认定朴槿惠多项嫌疑查看:353次
-
 11页2017-03-07
法国大选:菲永坚持参选查看:335次
11页2017-03-07
法国大选:菲永坚持参选查看:335次
-
 5页2017-03-07
伊拉克战事:狙击手出击查看:473次
5页2017-03-07
伊拉克战事:狙击手出击查看:473次
-
 12页2017-03-06
古城之殇:收复巴尔米拉查看:656次
12页2017-03-06
古城之殇:收复巴尔米拉查看:656次
-
 3页2017-03-03
中国海军:远海实兵演练查看:621次
3页2017-03-03
中国海军:远海实兵演练查看:621次
-
 7页2017-03-03
伊拉克战事:“围城”摩苏尔查看:535次
7页2017-03-03
伊拉克战事:“围城”摩苏尔查看:535次
-
 5页2017-03-02
三峡:累计发电1万亿千瓦时查看:394次
5页2017-03-02
三峡:累计发电1万亿千瓦时查看:394次
-
 10页2017-03-02
大盘点:中国“奔月”历程查看:1351次
10页2017-03-02
大盘点:中国“奔月”历程查看:1351次
-
 14页2017-03-02
非遗:这些项目你知道吗?查看:485次
14页2017-03-02
非遗:这些项目你知道吗?查看:485次
-
 40页2017-03-01
数据:2016年统计公报图表查看:8134次
40页2017-03-01
数据:2016年统计公报图表查看:8134次
-
 6页2017-03-01
伊拉克战事:激战摩苏尔查看:882次
6页2017-03-01
伊拉克战事:激战摩苏尔查看:882次
-
 11页2017-02-28
十位标兵:全国三八红旗手查看:1352次
11页2017-02-28
十位标兵:全国三八红旗手查看:1352次
-
 5页2017-02-28
上海“控烟令”:有多严?查看:764次
5页2017-02-28
上海“控烟令”:有多严?查看:764次